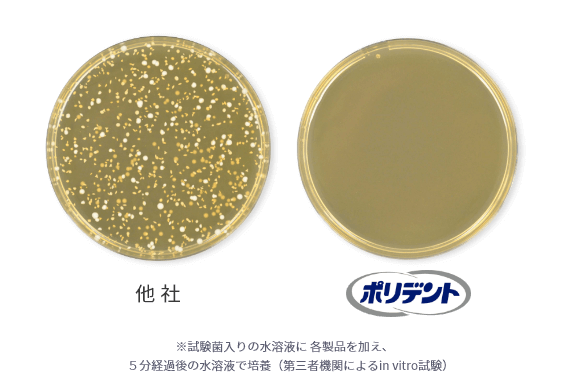

マウスピース洗浄剤はこちらの装具をご利用の方がお使いいただけます。

矯正用 マウスピース

矯正用 リテーナー

歯ぎしり用 マウスピース

スポーツマウスガード
製品情報
Product
タブレットタイプ
歯垢予防機能がプラス!
約6倍※1も
菌やヌメリの蓄積を防ぐ
3分 で気になるニオイの原因菌までも 除去・洗浄、99.9%※2除菌

タブレットタイプ
3分で
ニオイ菌・黄ばみ・ヌメリを
トリプル洗浄

とっても簡単!
マウスピース洗浄剤の使い方 3STEP
How to 3STEP

150mL程度のぬるま湯(体温程度※)に、本品を1錠入れます。
※お口の装具の材質や形状には、熱に弱く変形しやすいものもあります。歯科医師にご相談ください。

お口の装具全体を3分から一晩をめどに*洗浄液に浸してください。洗浄液に浸した後に、洗浄液をやわらかい歯ブラシ等につけて磨いてください。シリコンゴム製品は傷つく恐れがあるので、かたい歯ブラシで磨かないでください。
※一晩以上は不可

洗浄後は水でよくすすぎ、残った洗浄液はすぐに捨ててください。
使用方法は、製品の説明書きを必ずお読みください。